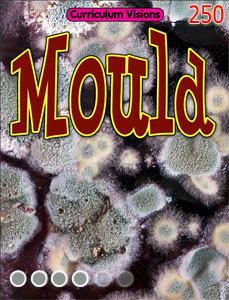
Mould

Your topic in video lessons
Video lessons…
- Microbes – an overview
- How microbes work: moulds
- Watching food decay
- Keeping disease at bay
- March of the mushrooms
- How microbes digest our food (section)
- Chew it through – Part 1
- Chew it through – Part 2
- Chew it through – Part 3
- Chew it through – Part 4